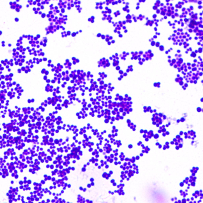
Profile picture

Tomasz Gosiewski
Habilitation
-
ProfessorJagiellonian University Medical CollegeKraków, Poland
